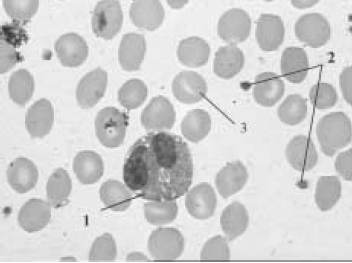
Enunciado 3992770-1

Um médico, na avaliação de paciente com suspeita de coagulopatia e sangramentos, solicitou os seguintes exames laboratoriais: hematócrito, hemoglobina, contagem de eritrócitos, leucograma, velocidade de hemossedimentação, tempo de trombina, tempo de tromboplastina parcial, tempo de tromboplastina parcial ativada, tempo de protrombina; fezes — parasitológico e pesquisa de sangue oculto.
Em face da situação acima descrita e de assuntos a ela relacionados, julgue os itens a seguir.
Na figura abaixo, os algarismos de 1 a 3 correspondem, respectivamente, a granulócito, plaquetas e eritrócito.